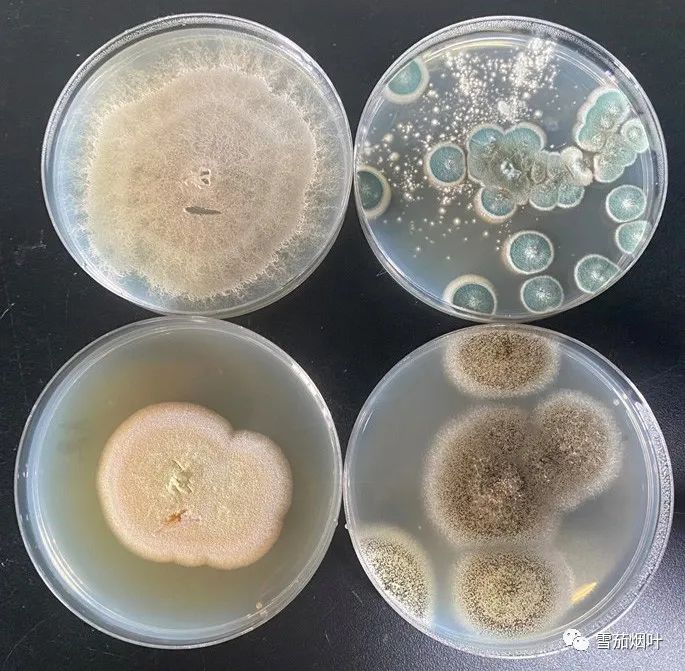
1.jpg
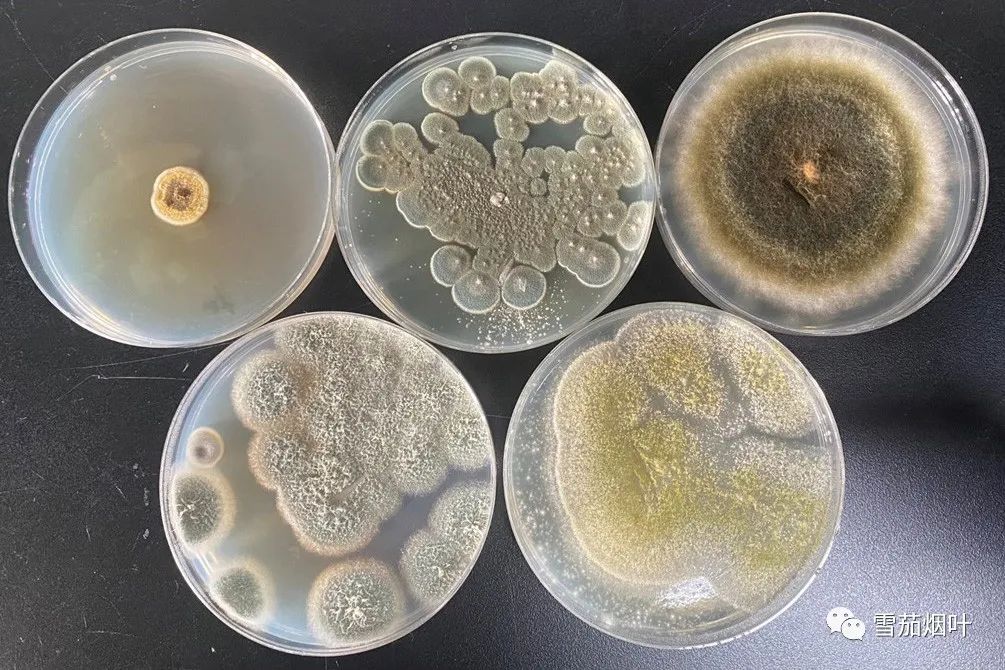
2.jpg

雪茄烟叶生霉,元凶竟是它!
2023-05-16
雪茄烟及其烟叶原料,在存放不当时,均有可能出现霉菌生长的情况。
为明确导致某产区雪茄烟叶霉变的元凶,我们尝试开展了以下工作。
首先,选取发生霉菌的烟叶样品一批,置于超净工作台中,用接种环挑取烟叶表面霉菌于PDA固体培养基中,在28℃恒温培养观察。
待长出菌落后,并用接种环挑取霉菌接种到PDA中做有规则的划线,经过多次划线得到纯种9株单菌株,其中4株为烟梗表面筛选,5株为叶肉表面筛选。
注:上图为烟梗提取菌株,从左到右,从上到下,依次编号为1~4
最终,分子生物学鉴定结果如下。
编号 | 英文名称 | 中文名称 |
1 | Aspergillus flavus | 黄曲霉 |
2 | Penicillium steckii | 岐皱青霉 |
3 | Aspergillus terreus | 土曲霉 |
4 | / | 硫球曲霉 |
5 | Aspergillus proliferans | 多育曲霉 |
6 | Penicillium citrinum | 桔青霉 |
7 | Alternaria alternata | 互生交链孢霉 |
8 | Talaromyces funiculosus | 绳状篮状菌 |
9 | PCR扩增失败 | |

关键词:
雪茄

